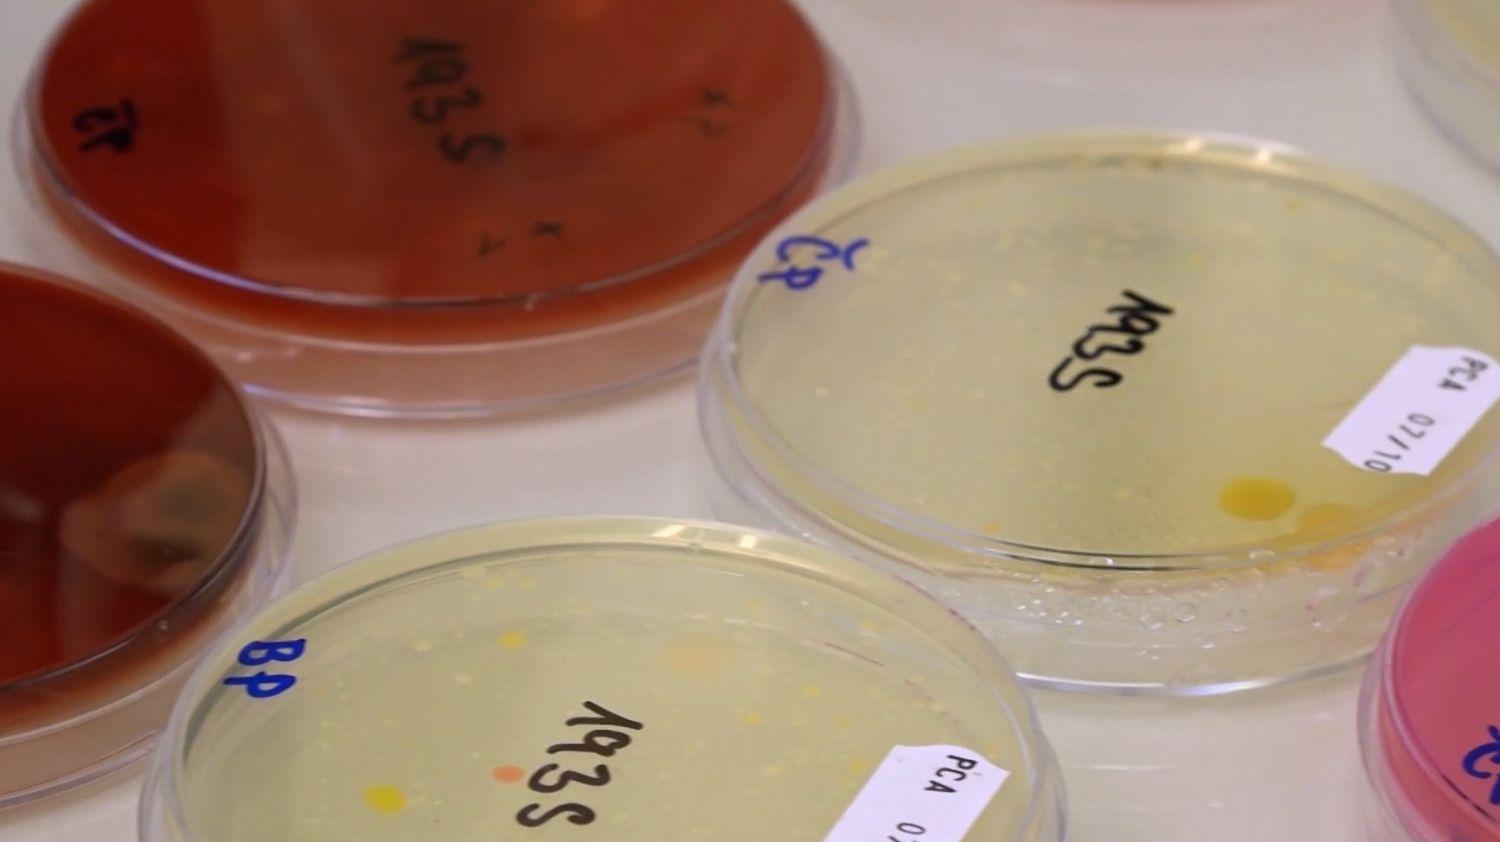

Respirátory je potřeba měnit a používat nové
Pracovnice v laboratoři Ústavu biochemie a mikrobiologie VŠCHT analyzovaly pro server Aktuálně.cz nejen dva dlouho nošené respirátory, ale také jeden zbrusu nový a čistý na výskyt mikroorganismů. Přinesené respirátory nejdříve rozstříhaly a jejich vnitřní filtrační vrstvu obtiskly na misky s příslušnými kultivačními médii. Při testování se zaměřily na výskyt bakterií, kvasinek a plísní.
Nejde o vědeckou studii, ale pouze o ilustrační příklad zřejmého faktu, že ve vzduchu se nachází mnoho různých mikroorganismů a jejich spor. S prodlužujícím se časem používání respirátoru se v něm mikroorganismy zachytávají. Je proto dobré respirátory často měnit a používat nové. Správně nošený respirátor je efektivní způsob, jak omezit přenos patogenů mezi lidmi.